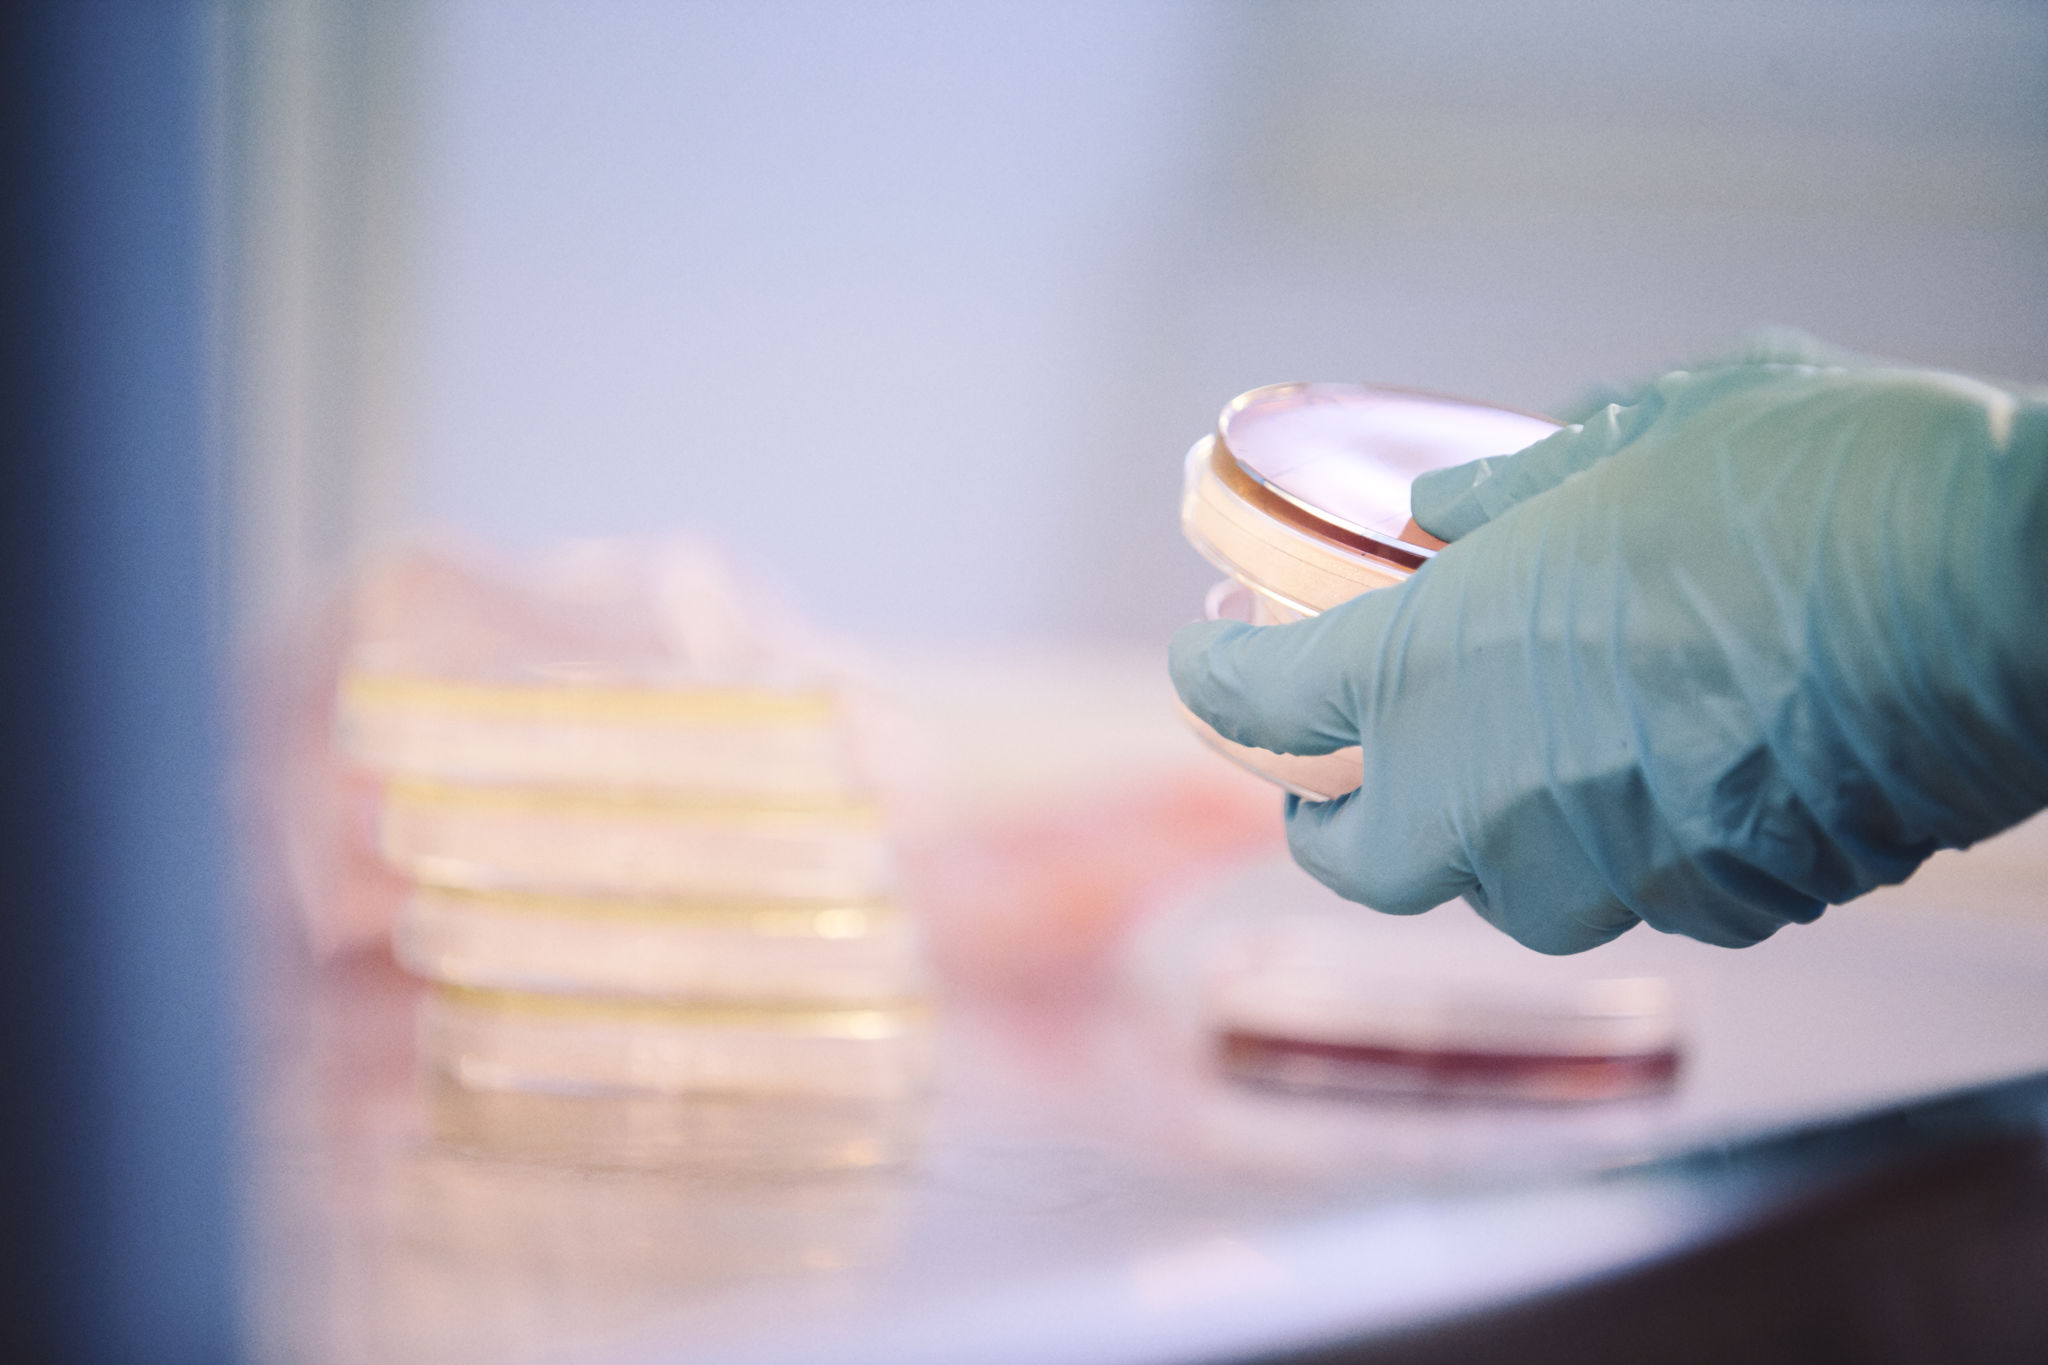
Cellodling.

Sök till magisterutbildning
Du som vill bygga på en tidigare kandidatexamen kan söka in till Åbo Akademis magisternivå. Hos oss får du studera det du brinner för i en internationell och tvärvetenskaplig omgivning. Magisterstudier utvecklar ditt analytiska tänkande och din förmåga att bearbeta komplexa helheter. Med en magisterexamen får du en stark vetenskaplig grund att stå på, som både ger dig olika arbetsmöjligheter och kvalificering för forskarstudier.
Du kan söka in till något av våra två-åriga magisterprogram med en kandidatexamen från ett universitet eller än lägre högskoleexamen från en yrkeshögskola. Du kan söka om du avlägger examen före utgången av det läsår då du söker in, dvs. före 31.7.2026. Du söker om rätt att avlägga magisterexamen i gemensam ansökan.
Ansökan till magisterutbildningar som ges på svenska vid Åbo Akademi sker i vårens andra gemensamma ansökan 10.3.2026 kl. 8.00 – 24.3.2026 kl. 15.00. Ansökan görs genom ansökningsblanketten på Studieinfo.fi.
Om du blivit antagen till Åbo Akademi för att avlägga både kandidat- och magisterexamen har du automatiskt rätt att fortsätta på magistersstudier inom den studierätt du har fått och behöver inte söka in på nytt. Om du däremot avlagt en kandidatexamen vid en annan högskola eller efter avlagd kandidatexamen vid ÅA vill söka in till ett sådant magisterprogram som inte ingår i din studierätt måste du söka in till programmet via gemensam ansökan.
Du kan söka in till de program du har ämnesbehörighet till, det vill säga att du uppfyller de förhandskunskapskrav som utbildningen ställer. Det betyder att du har kandidatexamen inom samma eller ett närliggande ämnesområde eller att du har tillräckligt mycket studier i det tilltänkta huvudämnet.
Om din kandidatexamen inte innehåller huvudämnesstudier eller andra behörighetsgivande studier i tillräcklig omfattning kan du bli uppmanad att komplettera din kandidatexamen med högst 60 studiepoäng (bryggstudier). De kompletterande studierna kan bedrivas parallellt med studierna för magisterexamen.
Till ansökan ska bifogas intyg över avlagda studier, se vår sida om bilagor för mera information.
Villkorligt antagen
Att bli villkorligt antagen innebär att du kan ta emot en studieplats du blir erbjuden, men att du inte kan göra läsårsanmälan förrän du uppfyller villkoret som ställts. Det framgår i Studieinfo om du blivit villkorligt antagen och vad villkoret i så fall är.
Ett vanligt villkor är ifall du får din lägre högskoleexamen först efter ansökningstidens slut. I så fall ska du ladda upp intyg över examen du håller på att avlägga (ett aktuellt studieprestationsutdrag) till din ansökan innan 31.3.2026 kl. 15:00. Du kan komplettera din ansökan med ett studieprestationsutdrag över sådana kurser du avlägger under våren fram tills 29.5.2026. På basis av dessa dokument kan du bli villkorligt antagen, med villkoret att du innan 31.7.2026 får din lägre högskoleexamen.
Om du blir villkorligt antagen så ska du så fort du fått ditt examensbetyg lämna in en skannad kopia av betyget till admission@abo.fi. Ditt examensbetyg behöver vara utfärdat senast 31.7.2026 och du måste lämna in ditt examensbetyg innan du kan närvaroanmäla dig för läsåret.
Då vi har kontrollerat att du uppfyller villkoret som ställs ändrar vi sedan din ansökans status till att inte längre vara villkorlig, vilket innebär att du sedan t.ex. kan göra läsårsanmälan.
Om du inte uppfyller det villkor som ställs inom utsatt tid annulleras ditt antagningsbeslut.
Engelskspråkiga magisterprogram
Förutom svenskspråkiga magisterprogram erbjuder Åbo Akademi även engelskspråkiga magisterprogram. Ansökan till magisterutbildningar som ges på engelska vid Åbo Akademi sker inom Gemensam ansökans första ansökningsperiod 7.1.2026 kl. 8.00 – 21.1.2026 kl. 15.00